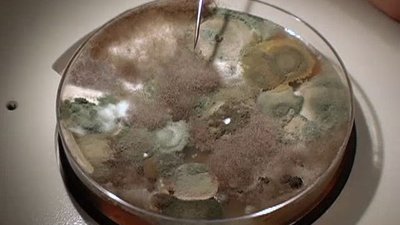
When Disaster Strikes Season 1 Episode 2

When Disaster Strikes Season 1 Episode 2 Mold
- October 1, 2006
When Disaster Strikes is a show that takes an in-depth look at different types of disasters, how they occur and how to prepare for them. In season 1 episode 2, titled "Mold", we explore the dangers of mold and how it can be a disaster in its own right.
Mold is a type of fungus that grows in damp or humid conditions. It thrives in areas such as bathrooms, basements, and attics where there might be a buildup of moisture. While not all molds are harmful, some can cause serious health issues, particularly for those with weakened immune systems.
The episode begins by introducing us to a family who recently moved into a new home. They noticed a strange smell coming from the basement and decided to investigate. To their horror, they found a significant amount of mold growing on the walls and ceiling. They also discovered that the previous owners had tried to cover up the problem instead of dealing with it, which only made the situation worse.
The family's first instinct was to clean the mold themselves using bleach. However, they soon learned that this was not only ineffective but also dangerous. Bleach can actually make the problem worse by releasing mold spores into the air.
To understand mold better, the show turned to an expert, Dr. Rachel C. Miller, a pediatrician who specializes in environmental health. Dr. Miller explains that mold can cause a variety of health problems, including asthma, allergies, and even neurological issues.
The show then dives deeper into the science behind mold and how it grows. We learn that mold needs organic matter, such as wood or drywall, and moisture to survive. If left unchecked, it can spread quickly and cause serious damage to a building's structure.
To prevent mold growth, the show recommends controlling moisture levels in the home. This can be done by using a dehumidifier, fixing leaky pipes, and ensuring proper ventilation in areas such as bathrooms and kitchens.
In addition to prevention, the show also explores how to remove mold safely. They emphasize the importance of hiring a professional mold removal company rather than attempting to do it yourself. Professionals have the necessary equipment and expertise to remove mold safely and effectively.
The episode also touches on the legal implications of mold. In some cases, landlords and homeowners can be held liable for mold-related health issues. It's essential to address mold problems promptly to avoid legal and financial consequences.
Overall, "Mold" is a thought-provoking episode that sheds light on a lesser-known disaster. It serves as an important reminder of the dangers of mold and the importance of taking preventative measures to avoid it.